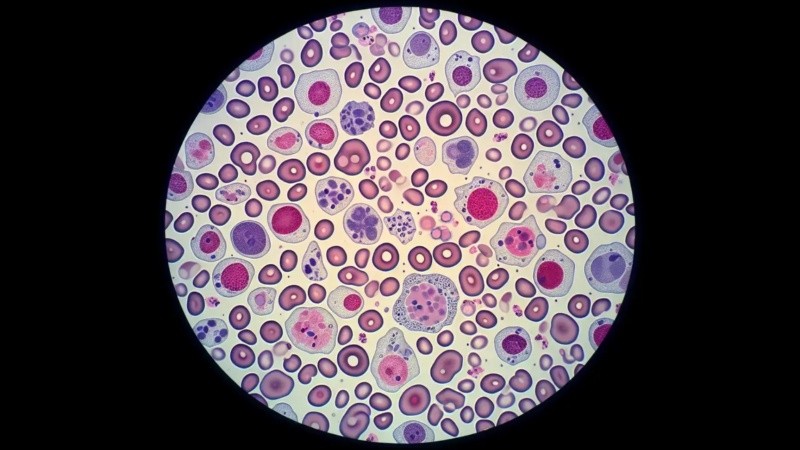
La pérdida de diversidad celular puede identificarse con la inflamación persistente en la vejez.

El sistema sanguíneo envejece con el correr de los años y comienza a degradarse puesto que la competencia entre las células madre que lo componen se desequilibra. Esta situación altera la producción de nuevas células sanguíneas y aumenta la posibilidad de sufrir enfermedades. Un nuevo estudio internacional, cuyos hallazgos se publicaron en Nature, consigue rastrear en humanos cada una de estas células hasta su progenitora original, lo que permite observar cambios en las marcas químicas adheridas al ADN (metilaciones) que indican cuáles son los genes que se activan o silencian.
Cuando una célula madre se divide, estas marcas se copian en las células hijas y dejan unos "códigos de barras" permanentes que los investigadores pueden leer para reconstruir el árbol genealógico celular. Según uno de los autores del estudio, “nuestras células portan cambios genéticos que colectivamente nos hacen individuos únicos, pero dentro de cada individuo, llevamos también un mosaico de alteraciones genéticas y epigenéticas”.
Llegar al origen de las células
Al conseguir leer las marcas en el ADN y saber cuál es el origen de cada célula como si se tratara de un "árbol genealógico" por medio de la técnica EPI-Clone, los investigadores lograron rastrear los "códigos de barras" y reconstruir la historia de la producción sanguínea para distinguir qué celulas contribuyen a la sangre y cuáles se van perdiendo con la edad.
Los científicos explicaron que la base de EPI-Clone eran los errores de metilación del ADN: "Cuando muchos de ellos son estables, nos permiten seguirlos a través de una técnica de secuenciación masiva aplicada a células individuales".
A partir de su estudio con ratones, dieron cuenta de que mientras la sangre joven contaba con miles de células madre diferentes que contribuían a la creación de partículas necesarias para el organismo, en la de especímenes de edad avanzada, el 70% de las células madre pertenecían a la misma familia.
La situación era parecida en los humanos, aunque el porcentaje exacto variaba entre una docena de donantes sanos, entre 35 y 70 años, que participaron en el estudio. Los que tenían más de 50 años contaban con menos diversidad de células.
Proceso de envejecimiento sanguíneo
El envejecimiento se produce cuando un solo tipo de células madre supera a sus vecinas y toma el control de la producción de sangre en la médula ósea, según explica el estudio.
En tal sentido, proliferan un tipo concreto de células mieloides que se relacionan con afecciones como la inflamación crónica, que es un factor de riesgo de enfermedades cardiovasculares y leucemia. Por ende, la expansión de estas células inicia la aparición de patologías de la sangre y otras inmunológicas en adultos de edad avanzada.
Al marcar los 50 años como la edad en la que la sangre comienza a envejecer, los científicos señalaron: “Cuando tengamos 60 años, esta familia celular ya habrá expandido por toda la médula ósea y generará trillones de células de este tipo en la sangre todos los días”.
Menos diversidad frente a las amenazas
El problema no solo es la generación masiva de este tipo de células, sino la pérdida de familias celulares y otros clones necesarios. “Estas expansiones son nocivas y restan diversidad al sistema haciéndolo menos robusto frente a cambios en el entorno”, argumentaron.
Además, las células madre sanguíneas compiten por sobrevivir, lo que genera un ecosistema rico en la juventud, pero que en la vejez produce la extinción de familias importantes: “Solo unas pocas toman el relevo y trabajan el doble para compensar, lo que reduce la diversidad y debilita la resiliencia del sistema sanguíneo”. En tal sentido, las células madre diversas pueden responder a diferentes tensiones, por lo que el predominio de un puñado de clones hace que todo el sistema sea más frágil.
Esta pérdida de diversidad celular puede identificarse con la inflamación persistente en la vejez. Un hecho que se repite tanto en ratones como humanos y que es una característica fundamental del envejecimiento de la sangre en todas las especies.
Terapias de rejuvenecimiento
En el futuro, los médicos podrían evaluar el comportamiento de las células madre que se han expandido (un proceso denominado hematopoyesis clonal) y frenar el envejecimiento de una persona antes de que desarrolle cualquier tipo de enfermedad.
Estudios en ratones demostraron que la eliminación selectiva de estos pequeños organismos con sesgos mieloides podría aumentar la producción de linfocitos para mejorar las respuestas inmunitarias.
Sin embargo, para llegar a los humanos, todavía deben identificar que clones son los problemáticos: "No podemos arreglar lo que no podemos ver, y por primera vez, EPI-Clone puede facilitar esto para las personas”. Asimismo, por el momento resultarían cuestiones muy onerosas por lo que continúan en investigación.
Fuente: SINC.